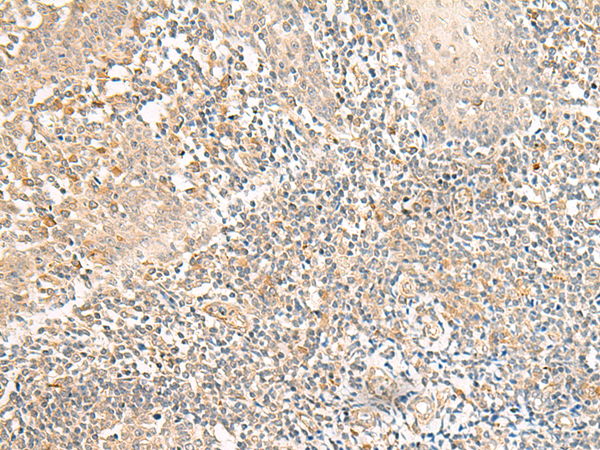

|
Background: |
Orphan receptor that promotes neuronal differentiation of radial glial progenitors (RGPs). The activity of this receptor is mediated by a G(q)-protein that activates a phosphatidylinositol-calcium second messenger. |
|
Applications: |
ELISA, IHC |
|
Name of antibody: |
GPR157 |
|
Immunogen: |
Synthetic peptide of human GPR157 |
|
Full name: |
G protein-coupled receptor 157 |
|
SwissProt: |
Q5UAW9 |
|
ELISA Recommended dilution: |
5000-10000 |
|
IHC positive control: |
Human tonsil |
|
IHC Recommend dilution: |
40-200 |
購物車
購物車 幫助
幫助
 021-54845833/15800441009
021-54845833/15800441009
